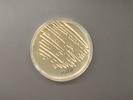

Michaeleen Doucleff appears in the following:
Breast Cancer Gene Test Helps Predict Who Can Skip Chemo
Monday, September 28, 2015
For the past 10 years, doctors have used a genetic test to decide which patients may be able to skip chemotherapy after surgery for breast cancer.
Now a study confirms that this test, called Oncotype DX, works well for a small group of patients. But a longer, follow-up study is ...
Could Delaying Retirement Be Great For Your Health?
Thursday, September 24, 2015
Deadly Heartland Virus Is Much More Common Than Scientists Thought
Wednesday, September 16, 2015
It's called the Heartland virus disease. Since it was first detected in 2009, there have been only nine reported cases in the Midwest, including two deaths.
So scientists thought the Heartland virus was limited to a small region.
That assumption was wrong.
A team at the Centers for Disease Control ...
Engineers Create A Titanium Rib Cage Worthy Of Wolverine
Tuesday, September 15, 2015
At first glance, the metallic device almost looks like a high-tech bike pedal. Or maybe the latest cooking gadget for zesting lemons. Or, perhaps, it's a secret weapon for X-Men superhero Wolverine.
But look again.
Doctors in Spain say this is the world's first 3-D-printed rib cage, made entirely ...
The World Is Running Out Of A Critical Snakebite Antidote
Wednesday, September 09, 2015
The Problem With Teens Is That They're Just Too Rational
Wednesday, September 09, 2015
Preemies' Survival Rates Improve, But Many Challenges Remain
Tuesday, September 08, 2015
These are the tiniest babies born. Some weigh only a pound or two. And can fit in the palm of your hand.
Extreme preemies — born somewhere between 22 and 28 weeks — have a better chance of surviving now than they did 20 years ago, doctors report Tuesday ...
As More Adults Pedal, Their Biking Injuries And Deaths Spike, Too
Wednesday, September 02, 2015
Zero Ebola Cases Reported In Sierra Leone, As Epidemic Peters Out
Thursday, August 20, 2015
The Ebola epidemic has entered a new phase. And it's a good one.
For the first time since the virus hit Sierra Leone, the country hasn't had a single new case in a week, the World Health Organization said Wednesday.
And over in Guinea and Liberia, the situation is ...
Engineers Make Narcotics With Yeast. Is Home-Brewed Heroin Next?
Friday, August 14, 2015
Can You Protect Your Tummy From Traveler's Diarrhea?
Thursday, August 06, 2015
It goes by many names: Delhi belly. Montezuma's revenge. The Aztec two-step. But doctors use one not-so-glamorous term: traveler's diarrhea.
If you're visiting a place this summer with less than ideal sewage disposal — maybe a resort in Mexico or a village in Rajasthan — chances are your GI tract ...
To Avoid Intestinal Distress While Traveling Overseas, Skip The Ceviche
Thursday, August 06, 2015
Ebola Vaccine Hailed As 'Game Changer' In Fight Against The Virus
Friday, July 31, 2015
Songs That Heal: Preserving A Thousand-Year-Old Tradition
Sunday, July 12, 2015
Only six people in the world know how to do what Sergio Pacheco is about to do.
A middle-aged man who rarely smiles, Pacheco stands in the middle of a crowd on the National Mall, wearing a feathered headdress, beaded necklace and wrinkled dress that's been hand painted with a ...
Cholera Vaccine Protects Whole Community, Even Unvaccinated
Friday, July 10, 2015
It's about the size of an "energy shot." You take it just like a shot of whiskey — bottoms up.
But this little ounce-and-a-half of liquid is more potent than caffeine or alcohol.
It's a cheap, oral vaccine against cholera. It could prevent deadly outbreaks, like the current one in ...
From Pygmy Hunting Songs To Taylor Swift, What Makes Music Universal
Thursday, July 09, 2015
No matter where you travel around the world, people share a few qualities. They cherish love for families and friends. They unite around good cooking. And they make music you can shake your booty to.
"Music is the universal language of mankind," Henry Wadsworth Longfellow wrote in first major work, ...
Health Officials Announce Return Of Ebola In Liberia
Wednesday, July 01, 2015
Ebola Returns To Liberia With A Mysterious Case Near Monrovia
Tuesday, June 30, 2015
Almost two months after Liberia was declared Ebola-free, the disease has cropped up again — this time in a rural town outside the capital city.
So far, there's only one new case, but health officials are rushing to stop its spread.
Liberia's deputy health minister, Tolbert Nyenswah, said Tuesday that ...
Pot For Parasites? Pygmy Men Smoke Out Worms
Tuesday, June 23, 2015
Compared to other cultures around the world, Americans are big stoners.
About 40 percent of Americans say they've tried marijuana at some point in their lifetimes, a large survey found. That rate was the highest reported across 17 countries, and it's nearly 10 times higher than the global average.
...As MERS Outbreak Surges, Genetic Tests Show Virus Hasn't Mutated
Monday, June 08, 2015
An outbreak of the Middle East respiratory syndrome, or MERS, has swelled to 95 cases in South Korea. Seven people have died, and scientists are trying to figure why the outbreak has grown so rapidly.
Although there's no vaccine or treatment for MERS, the disease isn't usually very contagious.
...